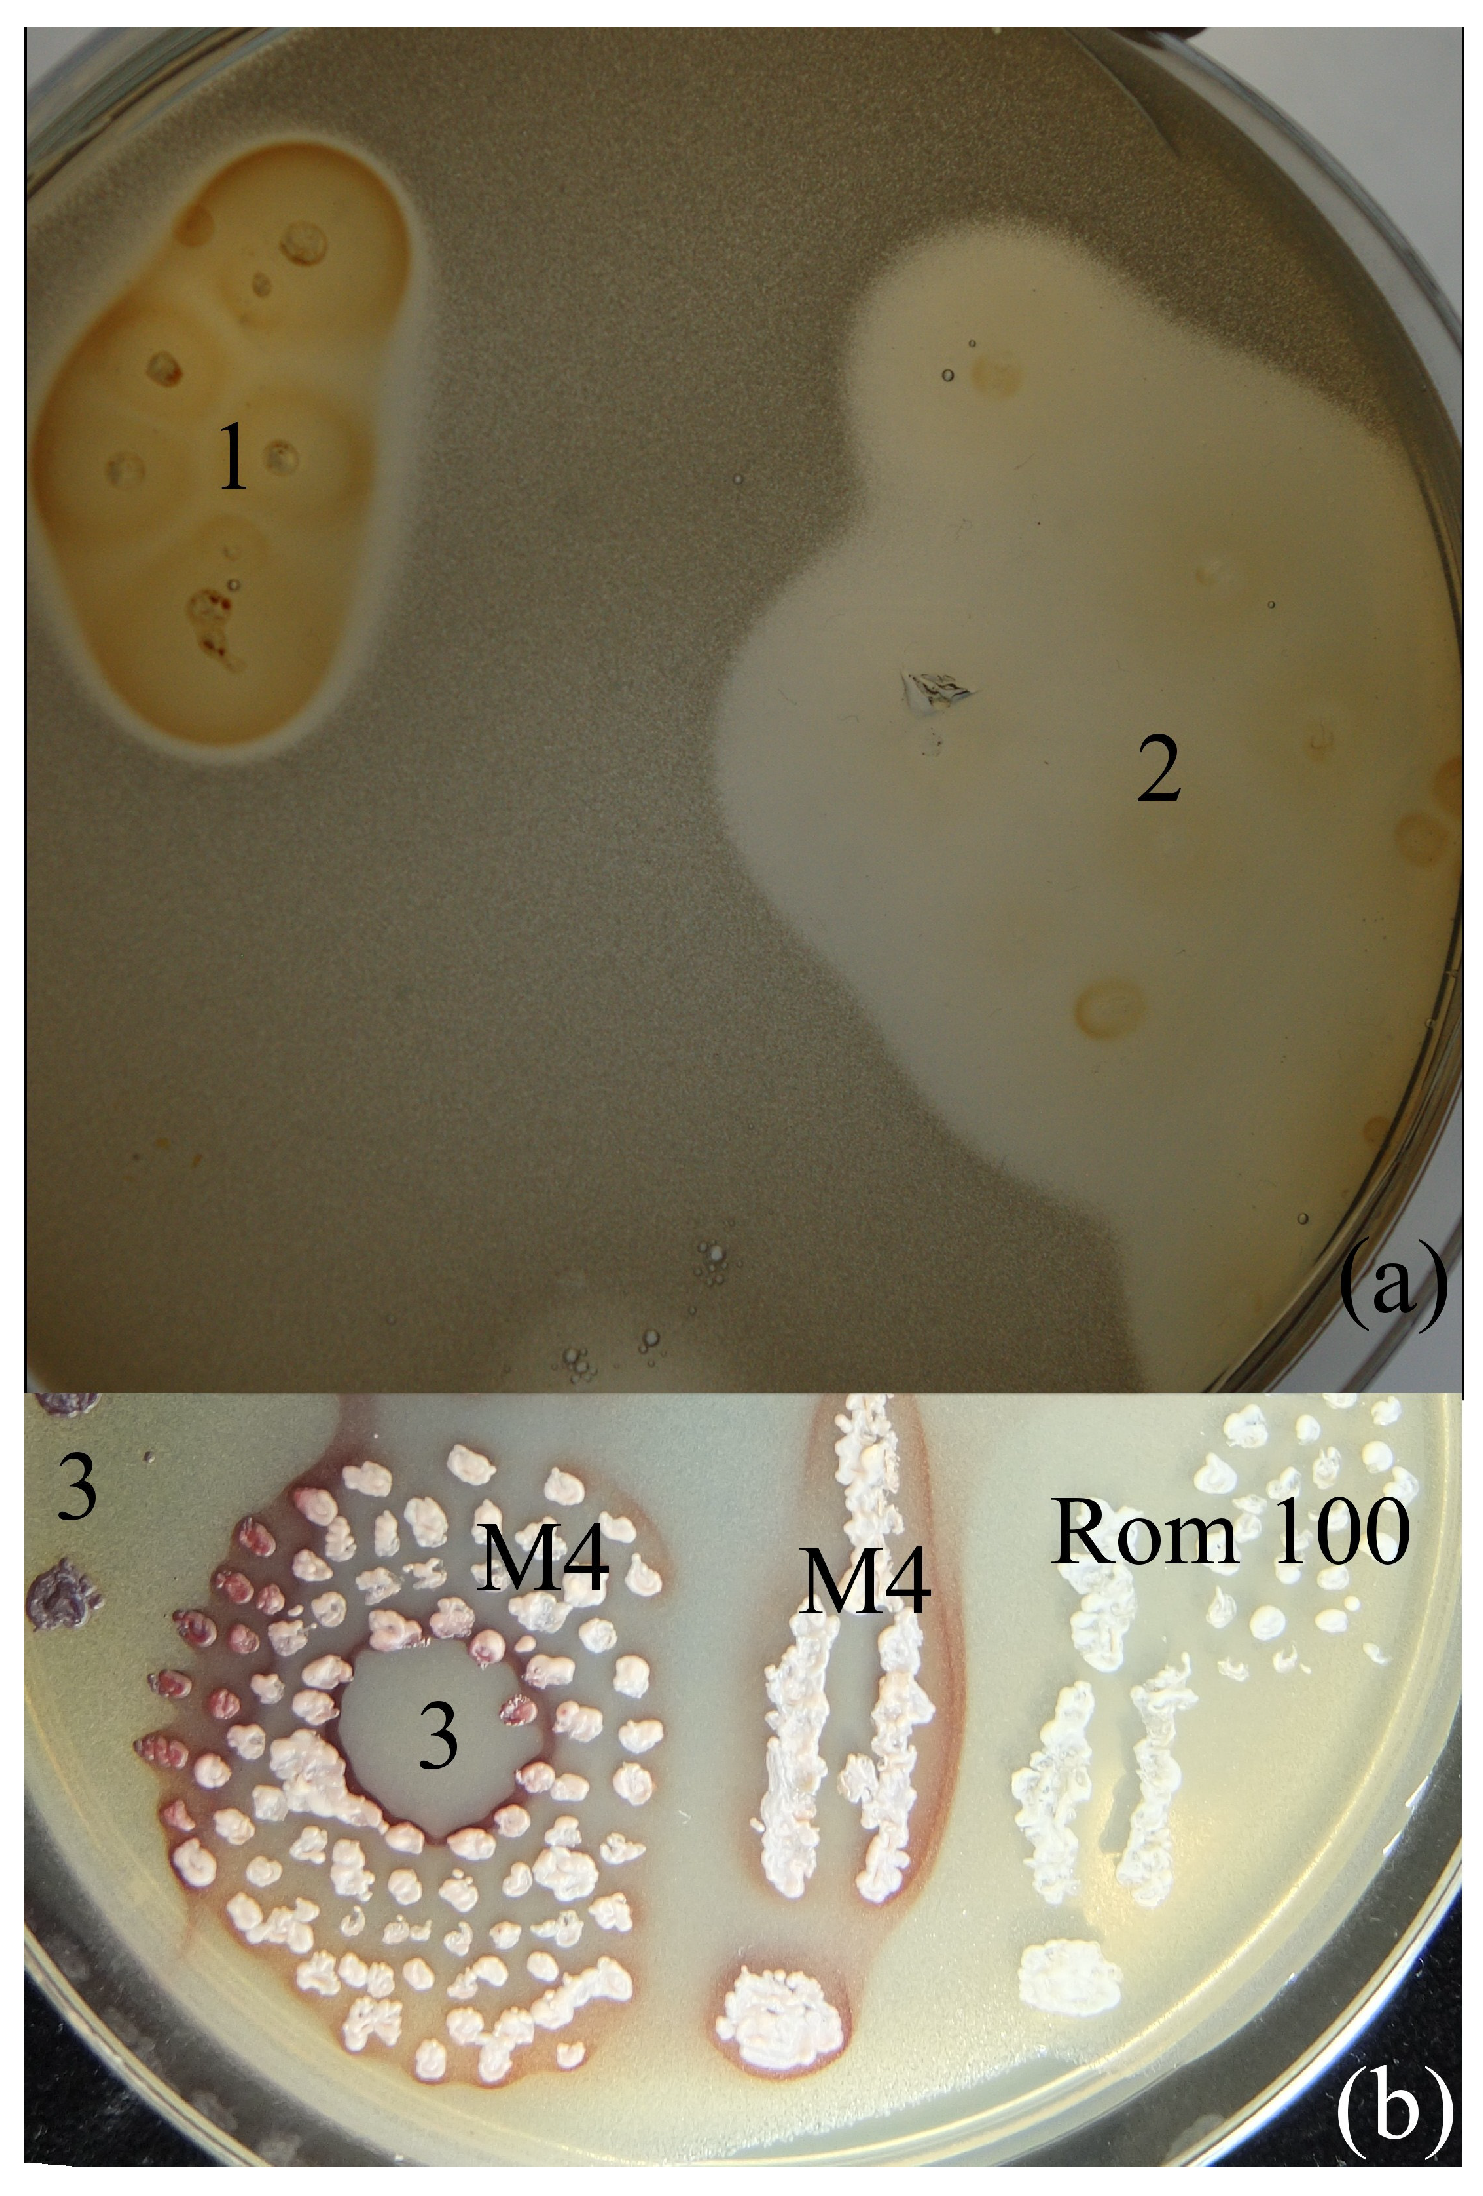

Reduction of Ferric Chloride in Yeast Growth Media, by Sugars and Aluminum
Abstract
1. Introduction
2. Results
3. Discussion
4. Materials and Methods
5. Conclusions
Author Contributions
Funding
Data Availability Statement
Conflicts of Interest
References
- Luidold, S.; Antrekowitsch, H. Hydrogen as a Reducing Agent: State-of-the-Art Science and Technology. JOM 2007, 59, 20–26. [Google Scholar] [CrossRef]
- Xing, Z.Y.; Lu, J.; Ji, X. A brief review of metallothermic reduction reactions for materials preparation. Small Methods 2018, 2, 1800062. [Google Scholar] [CrossRef]
- Mažeika, K.; Šiliauskas, L.; Skridlaite, G.; Matelis, A.; Garjonytė, R.; Paškevicius, A.; Melvydas, V. Features of iron accumulation at high concentration in pulcherrimin-producing Metschnikowia biomass. JBIC J. Biol. Inorg. Chem. 2021, 26, 299–311. [Google Scholar] [CrossRef] [PubMed]
- Melvydas, V.; Staneviciene, R.; Balynaite, A.; Vaiciuniene, J.; Garjonyte, R. Formation of self-organized periodic patterns around yeasts secreting a precursor of red pigment. Microbiol. Res. 2016, 193, 87–93. [Google Scholar] [CrossRef] [PubMed]
- Winterbourn, C.C. Toxicity of iron and hydrogen peroxide: The Fenton reaction. Toxicol. Lett. 1995, 82/83, 969–974. [Google Scholar] [CrossRef] [PubMed]
- Galaris, D.; Barbouti, A.; Pantopoulos, K. Iron homeostasis and oxidative stress: An intimate relationship. BBA-Mol. Cell Res. 2019, 1866, 118535. [Google Scholar] [CrossRef] [PubMed]
- Christides, T.P.; Sharp, P. Sugars increase non-heme iron bioavailability in human epithelial intestinal and liver cells. PLoS ONE 2013, 8, e83031. [Google Scholar] [CrossRef] [PubMed]
- Pulla Rao, C.; Geetha, K.; Raghava, M.S.S. Fe(III) complexes of D-glucose and D-fructose. BioMetals 1994, 7, 25–29. [Google Scholar]
- Maicas, S.; Mateo, J.J. The Life of Saccharomyces and Non-Saccharomyces Yeasts in Drinking Wine. Microorganisms 2023, 11, 1178. [Google Scholar] [CrossRef] [PubMed]
- Abeln, F.; Hicks, R.H.; Auta, H.; Moreno-Beltrán, M.; Longanesi, L.; Henk, D.A.; Chuck, C.J. Semi-continuous pilot-scale microbial oil production with Metschnikowia pulcherrima on starch hydrolysate. Biotechnol. Biofuels 2020, 13, 127. [Google Scholar] [CrossRef] [PubMed]
- Freimoser, F.M.; Rueda-Mejia, M.P.; Tilocca, B.; Migheli, Q. Biocontrol yeasts: Mechanisms and applications. World J. Microb. Biot. 2019, 35, 154. [Google Scholar] [CrossRef] [PubMed]
- Melvydas, V.; Svediene, J.; Skridlaite, G.; Vaiciuniene, J.; Garjonyte, R. In vitro inhibition of Saccharomyces cerevisiae growth by Metschnikowia spp. triggered by fast removal of iron via two ways. Braz. J. Microbiol. 2020, 51, 1953–1964. [Google Scholar] [CrossRef] [PubMed]
- Commenges, A.; Lessard, M.-H.; Coucheney, F.; Labrie, S.; Drider, D. The biopreservative properties of Metschnikowia pulcherrima LMA 2038 and Trichosporon asahii LMA 810 in a model fresh cheese, are presented. Food Biosci. 2024, 58, 103458. [Google Scholar] [CrossRef]
- Kregiel, D.; Czarnecka-Chrebelska, K.H.; Schusterová, H.; Vadkertiová, R.; Nowak, A. The Metschnikowia pulcherrima clade as a model for assessing inhibition of Candida spp. and the toxicity of its metabolite, pulcherrimin. Molecules 2023, 28, 5064. [Google Scholar] [CrossRef] [PubMed]
- Pawlikowska, E.; James, S.A.; Breierova, E.; Kregiel, H.A.D. Biocontrol capability of local Metschnikowia sp. isolates. Antonie Van Leeuwenhoek J. Microb. 2019, 112, 1425–1445. [Google Scholar] [CrossRef] [PubMed]
- Sipiczki, M. Metschnikowia pulcherrima and related pulcherrimin-producing yeasts: Fuzzy species boundaries and complex antimicrobial antagonism. Microorganisms 2020, 8, 1029. [Google Scholar] [CrossRef] [PubMed]
- MacDonald, C. The structure of pulcherriminic acid. Can. J. Chem. 1963, 41, 165–172. [Google Scholar] [CrossRef]
- Charron-Lamoureux, V.; Haroune, L.; Pomerleau, M.; Hall, L.; Orban, F.; Leroux, J.; Rizzi, A.; Bourassa, J.-S.; Fontaine, N.; d’Astous, É.V.; et al. Pulcherriminic acid modulates iron availability and protects against oxidative stress during microbial interactions. Nat. Commun. 2023, 14, 2536. [Google Scholar] [CrossRef] [PubMed]
- Zhike, W.; Jianting, C.; Cunling, Y. Application of ferric chloride both as oxidant and complexant to enhance the dissolution of metallic copper. Hydrometallurgy 2010, 105, 69–74. [Google Scholar] [CrossRef]
- Cakır, O. Chemical etching of aluminium. J. Mater. Process. Technol. 2008, 199, 337–340. [Google Scholar] [CrossRef]
- Ogura, Y.; Kobayashi, C.; Ooba, Y.; Yahata, N.; Sakamoto, H. Low temperature deposition of metal films by metal chloride reduction chemical vapor deposition. Surf. Coat. Technol. 2006, 200, 3347–3350. [Google Scholar] [CrossRef]
- Lee, C.S.; Robinson, J.; Chonga, M.F. A review on application of flocculants in wastewater treatment. Process Saf. Environ. 2014, 92, 489–508. [Google Scholar] [CrossRef]
- So, R.C.; Carreon-Asok, A.C. Molecular design, synthetic strategies, and applications of cationic polythiophenes. Chem. Rev. 2019, 119, 11442–11509. [Google Scholar] [CrossRef] [PubMed]
- Li, L.; Sun, J.; Cai, C.; Wang, S.; Pei, H.; Zhang, J. Corn stover pretreatment by inorganic salts and its effects on hemicellulose and cellulose degradation. Bioresour. Technol. 2009, 100, 5865–5871. [Google Scholar] [CrossRef] [PubMed]
- Zhang, H.; Li, N.; Pan, X.; Wu, S.; Xie, J. Oxidative conversion of glucose to gluconic acid by iron(III) chloride in water under mild conditions. Green Chem. 2016, 18, 2308–2312. [Google Scholar] [CrossRef]
- Žalneravičius, R.; Paškevičius, A.; Kurtinaitiene, M.; Jagminas, A. Size-dependent antimicrobial properties of the cobalt ferrite nanoparticles. J. Nanopart. Res. 2016, 18, 300. [Google Scholar] [CrossRef]
- Sun, H.-Q.; Lu, X.-M.; Gao, P.-J. The exploration of the antibacterial mechanism of Fe3+ against bacteria. Braz. J. Microb. 2011, 42, 410–414. [Google Scholar] [CrossRef]
- Huang, M.; Wang, Z.; Yao, L.; Zhang, L.; Gou, X.; Mo, H.; Li, H.; Hu, L.; Zhou, X. Ferric chloride induces ferroptosis in Pseudomonas aeruginosa and heals wound infection in a mouse model. Int. J. Antimicrob. Agents 2023, 61, 106794. [Google Scholar] [CrossRef]
- Zhen, W.; Lia, H.; Zhou, W.; Lee, J.; Liu, Z.; An, Z.; Xu, D.; Mo, H.; Hu, L.; Zhou, X. Ferrous sulfate-loaded hydrogel cures Staphylococcus aureus infection via facilitating a ferroptosis-like bacterial cell death in a mouse keratitis model. Biomaterials 2022, 290, 121842. [Google Scholar] [CrossRef]
- Karathia, H.; Vilaprinyo, E.; Sorribas, A.; Alves, R. Saccharomyces cerevisiae as a model organism: A comparative study. PLoS ONE 2011, 6, e16015. [Google Scholar] [CrossRef] [PubMed]
- Duina, A.A.; Miller, M.E.; Keeney, J.B. Budding yeast for budding geneticists: A primer on the Saccharomyces cerevisiae model system. Genetics 2014, 197, 33–48. [Google Scholar] [CrossRef] [PubMed]
- Foley, E.; Moyle, F.J. The reduction of ferric chloride by aluminium in aluminium chloride melts. J. Appl. Chem. Biotechnol. 1972, 22, 867–875. [Google Scholar] [CrossRef]
- Melvydas, V.; Mazeika, K.; Matelis, A.; Paskevicius, A.; Garjonyte, R. Response of pulcherrimin-producing Metschnikowia yeast to solid iron-containing materials: In vitro and in vivo studies. Mycologia, (submitted, under review).
- Thrane, N.; Trumpy, G. Spin-spin relaxation and Karyagin-Gol’danskii effect in FeCl3 6H2O. Phys. Rev. B 1970, 1, 153–155. [Google Scholar] [CrossRef]
- Stefansson, A. Iron(III) hydrolysis and solubility at 25 °C. Environ. Sci. Technol. 2007, 41, 6117–6123. [Google Scholar] [CrossRef] [PubMed]
- Irto, A.; Cigala, R.M.; De Stefano, C.; Crea, F. Advances in iron(III) hydrolysis studies. Effect of the metal concentration, ionic medium and ionic strength. J. Mol. Liq. 2023, 1, 123361. [Google Scholar] [CrossRef]
- Millero, F.J.; Yao, W.; Aicher, J. The speciation of Fe(II) and Fe(III) in natural waters. Mar. Chem. 1995, 50, 21–39. [Google Scholar] [CrossRef]
- Cotton, S.A. Iron(III) chloride and its coordination chemistry. J. Coord. Chem. 2018, 71, 3415–3443. [Google Scholar] [CrossRef]
- Neilands, J.B. Methodology of siderophores. In Siderophores from Microorganisms and Plants; Clarke, M.J., Goodenough, J.B., Ibers, J.A., Jorgensen, C.K., Mingos, D.M.P., Neilands, J.B., Palmer, G.A., Reinen, D., Sadler, P.J., Weiss, R., Eds.; Springer: Berlin, Germany, 1984; pp. 1–25. [Google Scholar]
- Murphy, J.M.; Powell, B.A.; Brumaghim, J.L. Stability constants of bio-relevant, redox-active metals with amino acids: The challenges of weakly binding ligands. Coord. Chem. Rev. 2020, 412, 212253. [Google Scholar] [CrossRef]
- Bull, J.N.; Maclagan, R.G.A.R.; Fitchett, C.M.; Craighead Tennant, W. A new isomorph of ferrous chloride tetrahydrate: A 57Fe Mossbauer and X-ray crystallography study. J. Phys. Chem. Sol. 2010, 71, 1746–1753. [Google Scholar] [CrossRef]
- Charley, P.J.; Sarkar, B.; Stitt, C.F.; Saltman, P. Chelation of iron by sugars. Biochim. Biophys. Acta 1963, 69, 313–321. [Google Scholar] [CrossRef] [PubMed]
- Kótai, L.; Lippart, J.; Gács, I. Deuterium isotope separation in the chemical reaction of aluminium amalgam and water. Eur. Chem. Bull. 2012, 1, 37–38. [Google Scholar] [CrossRef]
- Mažeika, K.; Reklaitis, J.; Nicolenco, A.; Vainoris, M.; Tsyntsaru, N.; Cesiulis, H. Magnetic state instability of disordered electrodeposited nanogranular Fe films. J. Magn. Magn. Mat. 2021, 540, 168433. [Google Scholar] [CrossRef]

| Sample | I, % | δ, mm/s | Δ, mm/s | |
|---|---|---|---|---|
| FeSO4·7H2O | 35 (34 ± 1) * | 0.427 ± 0.004 | 0.695 (0.66 ± 0.01) | Fe3+ |
| 65 (35 ± 1; 31 ± 1) | 1.245 ± 0.004 | 2.36 (1.97 ± 0.02; 2.75 ± 0.01) | Fe2+ | |
| FeCl3·6H2O | 74 (73 ± 1) | 0.423 ± 0.002 | 0.656 (0.63 ± 0.01) | Fe3+ |
| 26 (27 ± 1) | 1.215 ± 0.010 | 2.33 (2.44 ± 0.02) | Fe2+ |
| Sample | I, % | Γ, mm/s | δ, mm/s | Δ, mm/s | B, T | |
|---|---|---|---|---|---|---|
| FeCl3·6H2O | 100 | 1.07 ± 0.05 * | 0.41 ± 0.01 | 0.94 ± 0.01 | Fe3+ | |
| FeClFP0d (1:1) | 100 | 0.83 ± 0.05 | 0.40 ± 0.03 | 0.60 ± 0.06 | Fe3+ | |
| FeClFP1–2d (1:1) | 74 ± 2 | 0.55 ± 0.02 | 0.37 ± 0.13 | 0.40 ± 0.01 | Fe3+ | |
| 26 ± 2 | 0.91 ± 0.09 | 1.14 ± 0.04 | 2.39 ± 0.07 | Fe2+ | ||
| FeClFP1d (2:1) | 32 ± 1 | 0.50 ± 0.04 | 0.36 ± 0.01 | 0.41 ± 0.02 | Fe3+ | |
| 68 ± 1 | 0.28 ± 0.01 | 1.17 ± 0.01 | 2.35 ± 0.01 | Fe2+ | ||
| FeClFP4d (1:1) | 41 ± 2 | 0.57 ± 0.09 | 0.37 ** | 0.40 ± 0.04 | Fe3+ | |
| 59 ± 3 | 0.67 ± 0.09 | 1.11 ± 0.02 | 2.28 ± 0.04 | Fe2+ | ||
| FeClFAl1d (1:1) | 24 ± 1 | 0.53 ± 0.04 | 0.37 ** | 0.37 ± 0.02 | Fe3+ | |
| 29 ± 1 | 0.76 ± 0.04 | 1.16 ± 0.01 | 2.49 ± 0.03 | Fe2+ | ||
| 47 ± 1 | 0.33 ± 0.01 | 0.00 ± 0.01 | 0.00 ± 0.01 | 33.17 ± 0.02 | Fe0 | |
| After washing FeClFAl1d | 100 | 0.33 ± 0.02 | 0.00 ± 0.01 | −0.01 ± 0.01 | 33.23 ± 0.03 | Fe0 |
| FeCl3·6H2O on Al | 20 ± 1 | 0.33 ± 0.03 | 0.36 ± 0.05 | 0.71 ± 0.11 | Fe3+ | |
| 70 ± 2 | 0.36 ± 0.01 | 1.14 ± 0.02 | 2.28 ± 0.04 | Fe2+ | ||
| 10 ± 2 | 0.34 ± 0.02 | 0.00 ± 0.06 | 0.00 ** | 33.7 ± 0.4 | Fe0 | |
| FeClFAlp1d | 2 ± 1 | 0.20 ± 0.09 | 0.46 ± 0.04 | 0.22 ± 0.05 | Fe3+ | |
| (1:1:1) | 30 ± 1 | 0.45 ± 0.01 | 1.15 ± 0.01 | 2.28 ± 0.01 | Fe2+ | |
| 68 ± 1 | 0.30 ± 0.01 | 0.01 ± 0.01 | 0.01 ± 0.01 | 33.2 ± 0.01 | Fe0 | |
| Washed | 19 ± 2 | 0.6 ± 0.2 | 0.29 ± 0.05 | 0.69 ± 0.09 | Fe3+ | |
| FeClFAlp1d | 81 ± 2 | 0.35 ± 0.01 | 0.00 ± 0.01 | 0.00 ± 0.01 | 33.18 ± 0.04 | Fe0 |
| FeSFP6d (1:1) | 88 ± 1 | 0.33 ± 0.01 | 0.42 ± 0.01 | 0.15 ± 0.01 | Fe3+ | |
| 12 ± 1 | 0.78 ± 0.09 | 1.24 ± 0.06 | 2.57 ± 0.08 | Fe2+ |
Disclaimer/Publisher’s Note: The statements, opinions and data contained in all publications are solely those of the individual author(s) and contributor(s) and not of MDPI and/or the editor(s). MDPI and/or the editor(s) disclaim responsibility for any injury to people or property resulting from any ideas, methods, instructions or products referred to in the content. |
© 2024 by the authors. Licensee MDPI, Basel, Switzerland. This article is an open access article distributed under the terms and conditions of the Creative Commons Attribution (CC BY) license (https://creativecommons.org/licenses/by/4.0/).
Share and Cite
Mažeika, K.; Melvydas, V.; Čepukoit, D. Reduction of Ferric Chloride in Yeast Growth Media, by Sugars and Aluminum. Inorganics 2024, 12, 137. https://doi.org/10.3390/inorganics12050137
Mažeika K, Melvydas V, Čepukoit D. Reduction of Ferric Chloride in Yeast Growth Media, by Sugars and Aluminum. Inorganics. 2024; 12(5):137. https://doi.org/10.3390/inorganics12050137
Chicago/Turabian StyleMažeika, Kęstutis, Vytautas Melvydas, and Dovilė Čepukoit. 2024. "Reduction of Ferric Chloride in Yeast Growth Media, by Sugars and Aluminum" Inorganics 12, no. 5: 137. https://doi.org/10.3390/inorganics12050137
APA StyleMažeika, K., Melvydas, V., & Čepukoit, D. (2024). Reduction of Ferric Chloride in Yeast Growth Media, by Sugars and Aluminum. Inorganics, 12(5), 137. https://doi.org/10.3390/inorganics12050137

